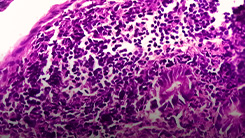
PediCRaFT: FMT in Pediatric Crohn’s Disease

HOW CAN WE HELP YOU? Call 1-800-TRY-CHOP
Pai Laboratory for Nutrition and Translational Microbiome Research
The Pai Lab investigates how the microbiome, nutrition, and host biology interact to influence health and disease in children. Research in the Pai Lab spans a wide range of pediatric gastrointestinal, metabolic, and nutritional disorders. The team leads multicenter clinical trials, studies host-microbial interactions in both clinical and translational models, and develops novel biomarkers to better personalize care for children.
This work bridges two translational institutional partnerships — McMaster University/McMaster Children's Hospital and the Children's Hospital of Philadelphia/University of Pennsylvania — with an active research team and collaborations across Canada, the United States, and internationally.
Research in the Pai Lab aims to harness the latest in technology and informatics to develop new treatments, and optimize existing ones for children in our care, in North America, and globally.
-
PediFETCh: FMT in Pediatric Ulcerative Colitis

-
PediCRaFT: FMT in Pediatric Crohn’s Disease
-
FIND Trial: Prebiotics for Pediatric Fatty Liver Disease

-
Biomarkers in Pediatric Fatty Liver Disease

-
Malabsorption and the Microbiome in CF

-
NeoGut: Biobanking for NEC Research

-
Early Feeding, Atopic Disease, Short Bowel Syndrome

-
FMT Trials in Anorexia Nervosa and SIBO

-
Ongoing Collaborative Projects

